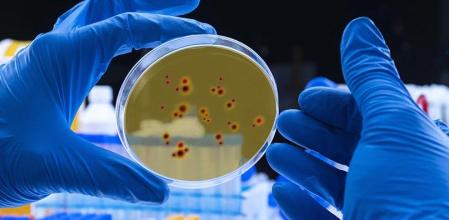
Científico examina el virus del dengue en placa de petri en laboratorio

Medidas extremas en Catalunya para contener un posible aumento del dengue
Escasa transmisión local
La mayoría de los casos detectados son importados, de personas que llegaron a Catalunya ya contagiadas
Científico examina el virus del dengue en placa de petri en laboratorio
La Generalitat está extremando el control y la vigilancia para “alejar” un posible escenario de transmisión más generalizada del dengue dentro de Catalunya, algo que por el momento es minoritario, pero que las condiciones climáticas y la proliferación del mosquito tigre podrían cambiar en los próximos años. Los Departamentos de Salud, Territorio, Agricultura e Interior de la Generalitat han presentado este viernes en rueda de prensa las acciones que, de forma coordinada, están llevando a cabo para luchar contra la propagación de las arbovirosis.
Se trata de enfermedades causadas por un grupo de virus de origen tropical que se transmiten a los humanos a través de mosquitos, especialmente el mosquito tigre (que transmite el dengue y ya ha colonizado 743 municipios catalanes) y el mosquito común (que puede portar el virus del Nilo).
El subdirector general de Vigilancia y Respuesta a Emergencias en Salud de la Generalitat, Jacobo Mendioroz, ha destacado este viernes que Catalunya tiene las “condiciones climáticas y de vectores –mosquitos que transmiten–” para que un virus como el del dengue se vuelva “autóctono”, es decir, que alguien pueda contagiarse sin haber salido de la comunidad autónoma, simplemente por la picadura de un mosquito. No obstante, la mayoría de los casos detectados son importados, de personas que llegaron a Catalunya ya contagiadas.
Solo 11 casos de transmisión autóctona desde 2022
Así, durante el periodo 2022-2024 se notificaron 1.591 casos sospechosos de arbovirosis, de los cuales 564 se confirmaron por laboratorio; de estos, solo un 2,1 % (11 casos) son de origen autóctono. De todos los casos confirmados (importados o autóctonos), el dengue es el más frecuente (93,6 % de los casos), mientras que el chikunguña, el zika y la fiebre del virus del Nilo Occidental son minoritarios: 4,1 %, 1,2 % y 1,1 %, respectivamente.
Entre 2022 y 2024 (de 2025 no hay registros porque los casos suelen producirse en agosto y septiembre), también se han confirmado tres brotes: dos personas en Reus (Baix Camp) con fiebre por virus del Nilo en 2022, dos personas con dengue en Malgrat de Mar (Maresme), y ocho personas por el mismo virus en Vila-seca (Tarragonès) en 2024.
Mendioroz atribuye que aún haya poca proporción de casos autóctonos al trabajo de vigilancia y control que llevan a cabo distintos servicios de la Generalitat, aunque admite que es posible que las transmisiones autóctonas vayan en aumento y que el dengue acabe convirtiéndose en endémico (es decir, que la enfermedad se instale y transmita de forma habitual en un territorio).
“No podemos hacernos ilusiones, no somos inmunes, pero todo lo que sea ganar tiempo y evitar casos cada año puede retrasar ese escenario”

En la misma línea, el secretario de Salud Pública, Esteve Fernández, ha afirmado que “sería ingenuo pensar” que Catalunya va a “librarse de que se vuelvan endémicas”, pero ha añadido: “Tampoco es algo que esté a la vuelta de la esquina”.
En este sentido, Fernández ha insistido en la necesidad de prevenir, tanto desde las instituciones como desde la ciudadanía.
Ha indicado que hay que evitar las picaduras de mosquito –usar ropa de manga larga, evitar zonas húmedas y aplicarse repelente–, así como no dejar agua estancada poco profunda cerca de las viviendas, ya que es donde los mosquitos ponen sus larvas.
Control del mosquito tigre o común
Por su parte, los Departamentos de Salud, Territorio, Agricultura e Interior están desplegando medidas de prevención, entre ellas el control del mosquito tigre y del mosquito común, así como la vigilancia de aves o caballos (estos últimos también pueden ser vectores del virus del Nilo).
Desde el punto de vista de la salud humana, Fernández ha subrayado la importancia de acudir al centro de salud si se detectan síntomas como malestar, fiebre o molestias tras una picadura. Este es un paso importante para poder hacer un diagnóstico y, a partir de ahí, controlar una posible transmisión a más personas –que siempre sería a través de mosquitos, no de persona a persona–, y vigilar el entorno y los insectos de la zona donde vive el infectado.